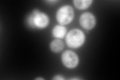
YPL240C
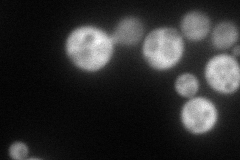
YPL240C
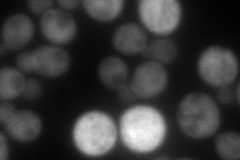
YPL240C
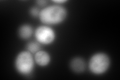
YPL240C
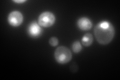
YPL240C
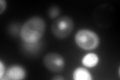
YPL240C

View description
Hsp90 chaperone required for pheromone signaling and negative regulation of Hsf1p; docks with Tom70p for mitochondrial preprotein delivery; promotes telomerase DNA binding and nucleotide addition; interacts with Cns1p, Cpr6p, Cpr7p, Sti1p
Localization:
Intensity:
Fold change:
Significance:
-
C’ GFP library in SD
cytosol668.14 -
N' NOP1pr-GFP in SD
cytosol107.225 -
N' TEF2pr-mCherry in SD
cytosol157.425 -
N' NATIVEpr-GFP in SD

cytosol165.698 -
N' TEF2pr-VC and Cyto-VN in SD

#N/A0 -
C’ GFP library in SD+DTT
cytosol1007.671.5Yes -
C’ GFP library in SD+H2O2

cytosol755.71.13No -
C’ GFP library in Starvation Media
nucleusN/AN/AYes -
C’ GFP library on the background of Pup2-DaMP
nucleus -
C’ GFP library on the background of CCT mutant

cytosol770.2261.15278No
